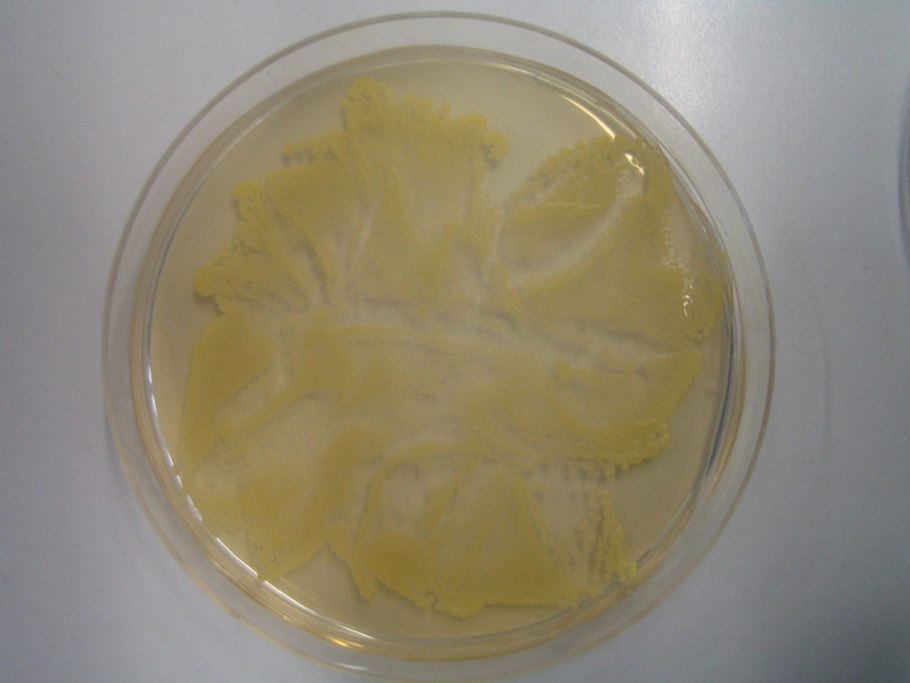
Медицина желтый

Пенталинон желтый

Pentalinon

Pentalinon

Алламанда махровая

Мандевилла Лютея вариегатная

Лаура Ботани

Мандевилла желтая

Алламанда в горшке

Солидаго цветок куст

Желтые цветы лекарственные травы

Золотарник Мимоза

Желтая Калина

ЕМУЛИЯ желтая трава

Алиссум скальный Summit

Жасмин де Грасиа

Желтая сорная трава

Таблетки в желтых капсулах

Капсула с жёлтым порошком наркотик

Желтые капсулы

Е104 желтый хинолиновый формула

Желтые витамины овальные

Магия желтого цвета

Желтый бетон

Цветы сенны

Желтые цветы с резными листиками

Золотая розга (золотарник)

Желтый порошок

Алиссум скальный

Желтая капсула лекарство

Пыльца кукурузы

Куркумин желтый порошок

Желтая окись свинца

Желтые круглые таблетки

Карбюратор leader pz19jb

Mdma желтые капсулы
Медицина желтый

Таблетки капсулы желтого цвета

Желтые капсулы

Медицина желтый





Поделиться фото в социальных сетях:
Комментариев (0)
Похожие фото:











